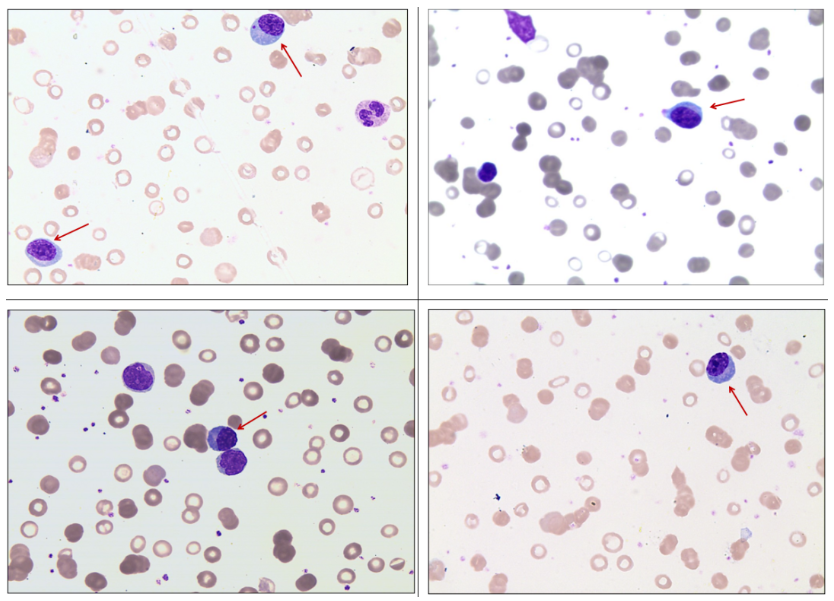

指导老师 | 黄霞梅 广西医科大学第一附属医院
前 言
淋巴浆细胞淋巴瘤/华氏巨球蛋白血症(LPL/WM)是一种少见的惰性成熟B细胞淋巴瘤,是由小B淋巴细胞、浆样淋巴细胞和浆细胞组成的淋巴瘤,常常侵犯骨髓,也可侵犯淋巴结和脾脏,并且不符合其他可能伴浆细胞分化的小B细胞淋巴瘤诊断标准,LPL侵犯骨髓同时伴有血清单克隆性IgM丙种球蛋白时诊断为WM。
本院有一病例,让我们来一起看看这个患者的“浆”湖险事。
案例经过
患者女,47岁,贫血貌。
主诉:自诉2月余前无明显诱因下出现乏力、心悸,活动后明显,且伴有双下肢水肿,呈晨轻暮重,偶有颜面水肿,至我院门诊就诊。
查体:双下颌、右颈部、左腹股沟可扪及一类圆形肿大淋巴结,最大位于双下颌,拇指大小,无压痛,边界清楚,活动度可,表面皮肤无红肿、破溃。余全身浅表淋巴结未扪及肿大。
患者入院血常规检测:(见图1)

图1
血常规提示患者白细胞高,表现为小细胞低色素性贫血。
外周血白细胞分类计数、红细胞形态学检测:(见图2)

图2
注:红色箭头所指细胞为浆细胞。
检查结果提示浆细胞增多,成熟红细胞轻度大小不等,部分中心浅染区扩大,呈缗钱状排列。结合以上结果,我们提出了疑问,患者是否为浆细胞疾病?
有疑问,我们就要验证,马上查看患者的其他实验室结果。
患者的生化检测:(见图3)

图3
结果提示总蛋白、球蛋白和尿酸都升高,肌酐清除率、血清铁降低。
再看患者的血清蛋白电泳、血清免疫固定电泳检测:(见图4)

图4
电泳结果提示血清中β微球蛋白降低,M蛋白可见,IgM和k轻链均有反应性。
还有患者的免疫球蛋白三项、血清铁蛋白检测:(见图5)

图5
检查结果提示免疫球蛋白M显著升高,血清铁蛋白降低。
结合已有的实验室检查,临床怀疑“缺铁性贫血、浆细胞白血病?”
由于患者拒绝进行浆细胞疾病相关的进一步检查,临床只能给予患者多糖铁胶囊补充造血原料和输注去白细胞悬浮红细胞2U,症状稍好转后,患者要求出院。
半个月后,患者再次来我院住院,并且入院以后完善了骨穿及相关检查。
骨髓细胞形态学检查结果如下:(见图6)


图6
检查结果发现浆细胞增多,还有一些浆样的淋巴细胞(红色箭头所指),这类细胞胞体小,胞质少而蓝,胞核较规则、偏位,染色质致密,核仁不明显。
综合以上报告结果,我们考虑淋巴增殖性肿瘤,LPL/WM可能性大,同时伴随缺铁性贫血。
为了验证此病,临床给患者做了其他相关性的实验室辅助检查。
骨髓活检结果:免疫组化:CD38小簇(+)、CD138小簇(+)、Kappa散在及小簇(+)、Lambda散在少(+)、CD3小结节状(+)、CD20结节状(+)、CD56(-)、Ki-67(15%+),提示浆细胞增多(约占10%),B淋巴细胞略增多。
骨髓免疫分型结果:见CD5-/CD10-的异常成熟B淋巴细胞占36.2%,异常浆细胞/浆样淋巴细胞占4.6%,限制性表达Kappa,据现有免疫表型特征,考虑为淋巴浆细胞淋巴可能性大。
基因诊断结果:MYD88L265P基因突变阴性,血清总蛋白91.6g/L,M蛋白条带:27.86g/L。
血清游离轻链组合:
①血清游离Kappa轻链:176.50mg/L;
②血清游离kappa/游离lambda:14.6473;
尿免疫固定电泳:
①尿本周氏蛋白电泳:ELP、κ轻链均阳性,尿本周氏蛋白阳性;
②尿蛋白电泳发现M蛋白条带,M:55.2%,24小时尿蛋白定量217mg/24h。尿免疫球蛋白κ轻链:77mg/L。
综合临床及实验室相关检查,患者最终被确诊为华氏巨球蛋白血症(WM)。
案例分析
LPL/WM主要见于老年人,临床表现为贫血、乏力、出血、脾肿大,肝、淋巴结也可肿大,还可有感染、雷诺现象、高黏滞综合征、神经系统症状等。LPL/WM无特异的形态学、免疫表型及遗传学改变,故LPL/WM的诊断是一个排他性诊断,需要紧密结合临床表现及病理学等检查结果进行综合诊断。虽然通过骨髓检查可协助诊断LPL/WM,但如有淋巴结肿大,仍建议尽可能获得淋巴结等其他组织标本进行病理学检查,除外其他类型淋巴瘤可能。
【WM中国诊疗指南(2022年版)诊断标准为】
1. 血清中检测到单克隆性IgM(不论数量)。
2. 骨髓中浆细胞样或浆细胞分化的小淋巴细胞呈小梁间隙侵犯(不论数量)。
3. 免疫表型:CD19(+),CD20(+),sIgM(+),CD5(-),CD10(-),CD22(+),CD23(-),CD25(+),CD27(+),FMC7(+),通常CD38和(或)CD138(+),而 CD103(-)。但是,10%~20%WM患者也可表CD5、CD10或CD23。
4. 除外其他已知类型的淋巴瘤。
5. 90%以上存在MYD88/L265P突变,此突变阴性的WM通常预后更差,DNA损伤修复基因(TP53/ATM/TRRAP)突变,特别是TP53缺失/突变是WM重要的不良预后因素。此突变有助于WM与其他惰性淋巴瘤及IgM型多发性骨髓瘤的鉴别诊断,但非特异性诊断指标,也可见于其他小B细胞淋巴瘤、弥漫大B细胞淋巴瘤等。另外30%WM患者存在CXCR4突变。
鉴别诊断
WM应与IgM型意义未明的单克隆免疫球蛋白血 症(MGUS)、多发性骨髓瘤(MM)等鉴别,疑难病例行骨髓荧光免疫原位杂交有助于诊断多发性骨髓瘤。
IgM 型 MM:IgM 型 MM 非常少见,细胞形态学为浆细胞形态,免疫表型为高表达 CD38、 CD138及CD56,而CD19、CD45多为阴性,常伴溶骨性损害等,这些特征是IgM型MM与WM鉴别的主要标志。MM 常伴有14q32(IGH)易位,在WM中罕见。
IgM 型 MGUS:IgM 型 MGUS 的诊断标准:①有血清单克隆IgM蛋白;②骨髓中无淋巴浆/ 浆细胞浸润;③无其他B淋巴细胞增殖性疾病的证 据;④无相关器官或组织受损的证据。
冒烟型骨髓瘤(SMM):血清M蛋白≥30
g/L或 24h尿轻链≥0.5g 或骨髓单克隆浆细胞比例≥10%和/或组织活检证明为浆细胞瘤;且无SLiM
CRAB表现(高钙血症、肾功能损害、贫血、骨病)。
无症状的WM患者无需治疗,WM治疗指征为 :明显乏力、B症状、症状性高黏滞血症;WM相关的周围神经病变;淀粉样变;冷凝集素病;冷球蛋白血症;髓外病变(特别是中枢神经系统病变)症状性淋巴结肿大或器官肿大。
总 结
由于患者一开始只是抽血检查,没有做骨穿及相关的检查,由于外周血涂片里面只看到浆细胞增高,并没有看到典型的浆样淋巴,有可能会误诊为浆细胞白血病,庆幸的是患者后续选择了继续入院检查及治疗。
血液病中的细胞千变万化、因人而异,有些细胞形态不典型,容易漏诊、误诊,需要结合临床及多方面的辅助检查才能确诊。有些患者因为各方面的原因,或者不了解疾病的严重性,可能会拒绝进一步检查,作为临床的辅助科室,一定要有一双火眼金睛和责任心,及时发现结果中的异常变化,积极与临床沟通,为患者的生命做好保障。在与死神赛跑的过程中一定要抢占先机,提早发现,提早治疗,给患者尽可能减少疾病带来的身体损伤及经济损失。
参考文献
[1]王霄霞,夏薇,龚道元.临床骨髓细胞检验形态学[M].北京:人民卫生出版社,2019:167-168.
[2]易树华, 李剑. 淋巴浆细胞淋巴瘤/华氏巨球蛋白血症诊断与治疗中国专家共识(2016 年版)[J].中华血液学杂志, 2016, 37(9):729-734.
[3]中国抗癌协会血液肿瘤专业委员会 中华医学会血液学分会 中国华氏巨球蛋白血症工作组.淋巴浆细胞淋巴瘤/华氏巨球蛋白血症诊断与治疗中国指南(2022年版)[J]中华血液学杂志,2022,43(08):624-630.
[4]中国医师协会血液科医师分会 中华医学会血液学分会.中国多发性骨髓瘤诊治指南(2022年修订)[J]中华内科杂志,2022,61(05):480-487.